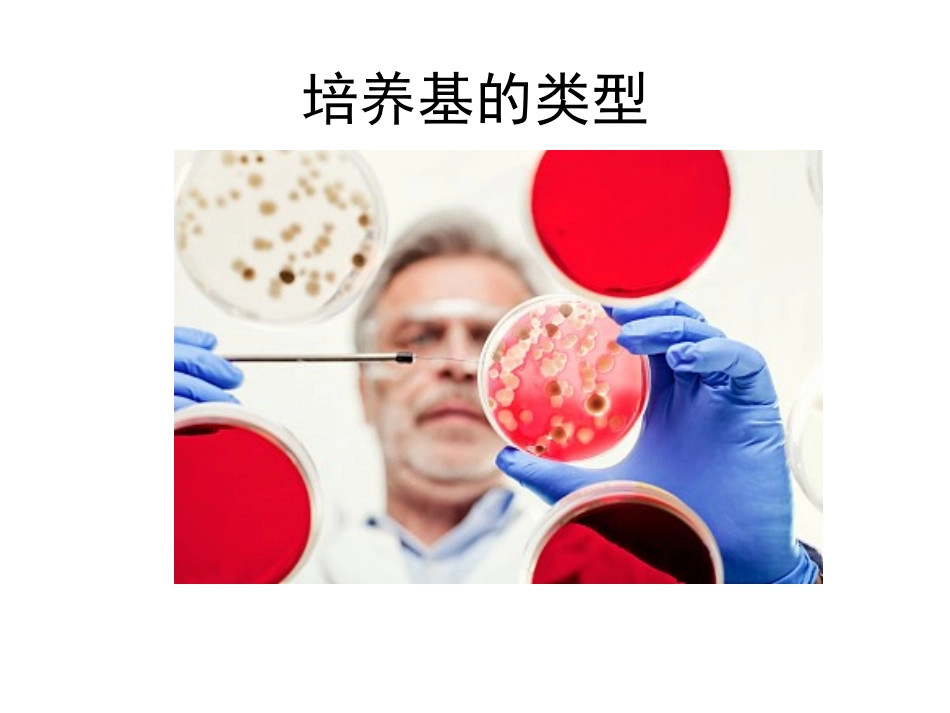

培养基的类型MicrobiologyLaboratory按培养基的物理状态分类按培养基的组成成分分类按所培养微生物的类群分类按培养基的功能(或用途)分类培养基的类型半固体培养基固体培养基液体培养基加富培养基鉴别培养基LOREM基础培养基选择培养基培养基的类型(按用途划分)基础培养基(minimummedium)含有一般微生物生长繁殖所需的基本营养成分的培养基
如牛肉膏蛋白胨培养基
可作为一些特殊培养基的基础成分
牛肉膏蛋白胨培养基配方:牛肉膏3g;水1000ml;琼脂15-20g;蛋白胨10g;NaCl5g;pH7
4培养基上的多种微生物菌落也称营养培养基,即在基本培养基中加入某些特殊的营养物质,如血、血清、酵母浸膏、动植物组织液或其他营养物质(生长因子)
加富培养基(enrichedmedium)一般用来培养营养要求比较苛刻的异养型微生物
培养百日咳博德特菌需要含有血液的加富培养基选择培养基是专门用来将某种或某类微生物从混杂的微生物群体中分离出来的培养基
根据不同种类微生物的特殊营养需求或对某种化学物质的敏感性不同,在培养基中加入特殊的营养物质或化学物质,抑制不需要的微生物的生长,促进目标微生物的生长,从而使目标微生物从混杂群体中分离出来
选择培养基(selectivemedium)培养基中不含氮源:分离固氮菌选择培养基A策略:依据某些微生物的特殊需求设计以蛋白质为唯一氮源:筛选出能产生胞外蛋白酶的微生物培养基中加酚:抑制细菌和霉菌生长,分离出放线菌
选择培养基B策略:加入特殊化学物质,对待分离微生物无害,但能抑制或杀死其它微生物放线菌扫描电镜图放线菌菌落培养基中加青霉素、四环素或链霉素:抑制细菌和放线菌生长,分离出酵母菌和霉菌
培养基中加亮绿或结晶紫:抑制G+菌生长,分离出G-菌
鉴别培养基(differentialmedium)根据微生物